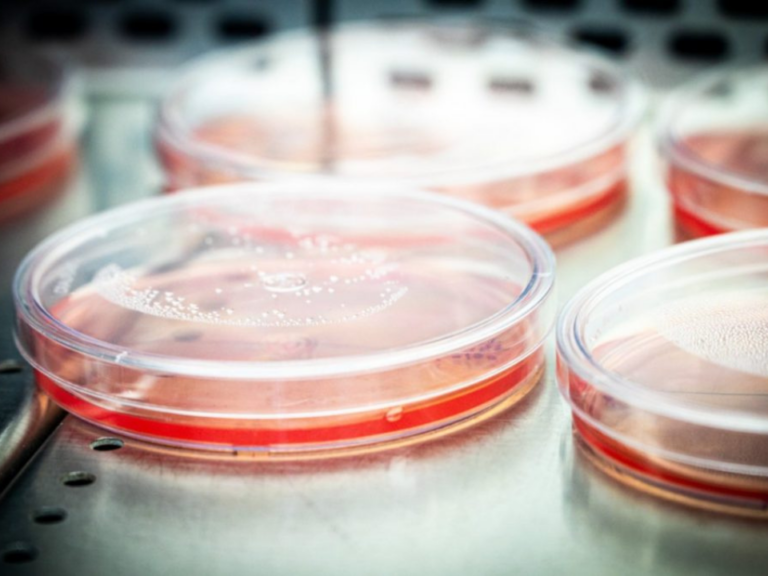

Bactérias, leveduras, fungos… Os produtos biológicos usados para controlar pragas, fertilizar o solo e tratar doenças das plantas ganharam um marco regulatório: o PL 658/2021. O texto foi aprovado no Congresso Nacional e aguarda a sanção presidencial. Mas por que o tema, tão relevante para a agropecuária, também é importante para a indústria?
O setor industrial possui potencial para investir em pesquisa e desenvolvimento tecnológico, fornecer recursos inovadores e garantir escalabilidade aos processos, especialmente no que diz respeito à diversificação da carteira de produtos de base biológica.
“Essas novas soluções baseadas em recursos biológicos e biotecnologia têm sido cada vez mais utilizadas por produtores rurais e são uma oportunidade para o fortalecimento de uma produção mais sustentável, visando à economia de baixo carbono e à ampliação da bioeconomia”, afirma o superintendente de Meio Ambiente e Sustentabilidade da Confederação Nacional da Indústria (CNI), Davi Bomtempo.
Os bioinsumos, amplamente usados em sinergia com outros defensivos, possibilitam uma produção agrícola que contribui para a conservação do meio ambiente e para a saúde do solo. Isso porque esses produtos atuam no crescimento e no desenvolvimento das plantas, melhoram a fertilidade do solo ou inibem pragas, representando uma alternativa sustentável.
Para se ter uma ideia do potencial do mercado de bioinsumos, o setor cresceu 15% na safra 2023/2024 em comparação à safra anterior, segundo dados da CropLife Brasil – associação que reúne empresas atuantes na pesquisa e no desenvolvimento de tecnologias em quatro áreas essenciais para a produção agrícola sustentável: germoplasma (mudas e sementes), biotecnologia, defensivos químicos e produtos biológicos.
Ainda de acordo com a CropLife Brasil, o mercado global de bioinsumos foi avaliado entre US$ 13 bilhões e US$ 15 bilhões em 2023, com uma previsão de crescimento anual entre 13% e 14%, alcançando US$ 45 bilhões até 2032. Além disso, entre os principais cultivos, 55% do total de uso de bioinsumos no Brasil são destinados à soja; 27% ao milho; 12% à cana-de-açúcar; e 6% ao algodão, café, citros e hortifruti.
Os números reforçavam a necessidade de o país ter regras claras para regulamentar a produção, a comercialização e o uso desses produtos. Até então, os bioinsumos estavam sob a tutela da Lei dos Defensivos Agrícolas, nº 14.785, de 27 de dezembro de 2023.
Produção on-farm
Uma das principais questões relacionadas ao marco regulatório é a produção de bioinsumos “on-farm”, ou seja, diretamente nas propriedades rurais. Nesse modelo, os insumos biológicos são produzidos na própria fazenda, em vez de serem adquiridos de fornecedores externos.
Durante o processo de negociação do texto, em reuniões com partes interessadas e audiências públicas, a CNI enfatizou que o PL deveria promover a coexistência entre a produção on-farm de bioinsumos e a produção industrial, garantindo segurança jurídica, inovação e escalabilidade.
Com a nova lei, a produção realizada dentro das fazendas para consumo próprio fica dispensada de registro, mas estará sujeita a um cadastro simplificado, ficando a critério do órgão de defesa agropecuária a dispensa desse cadastramento.
Já os locais onde os bioinsumos são produzidos para fins comerciais, chamados de biofábricas, deverão ter registro obrigatório no órgão federal de defesa agropecuária. Importadores, exportadores e comerciantes de bioinsumos também deverão realizar o registro.
O que ainda falta definir?
Para que a implementação da lei avance, é necessário definir as seguintes questões por meio de regulamento:
Classificação, especificações, parâmetros mínimos e outras exigências para registro de bioinsumos, consideradas a finalidade e a categoria de cada produto;
Registro de biofábricas, importadores, exportadores e comerciantes de bioinsumos;
Cadastramento simplificado das unidades de produção de bioinsumos;
Prioridade de aplicação de incentivos para microempresas, cooperativas e agricultura familiar que produzem bioinsumos;
Cobrança da Taxa de Registro de Estabelecimento e Produto da Defesa Agropecuária (TREPDA), aplicada à avaliação e alteração de registros que demandam análises técnicas de bioinsumos produzidos ou importados para fins comerciais, assim como aos estabelecimentos que produzem ou importam esses insumos;
Regras de suspensão e cancelamento de registro de produtos cuja produção, importação ou comercialização não tenha sido iniciada em até cinco anos após o registro;
Prazos e regras de transição para que todos os segmentos possam adequar-se aos procedimentos estabelecidos na lei, considerando as peculiaridades de cada categoria de produto.
Essas questões deverão ser definidas com apoio do Conselho Estratégico do Programa Nacional de Bioinsumos. O conselho é responsável por apoiar o planejamento estratégico e as ações voltadas à implementação do programa que visa ampliar e fortalecer a utilização de bioinsumos.
A CNI, uma das entidades empresariais integrantes do Conselho, conforme a Portaria do Ministério da Agricultura e Pecuária nº 130, de 2 de outubro de 2024, contribuirá para o avanço da regulamentação da nova legislação, bem como para outras discussões relacionadas ao tema.
Matéria – FIEB
Imagem – Foto: Gabriel Pinheiro / CNI